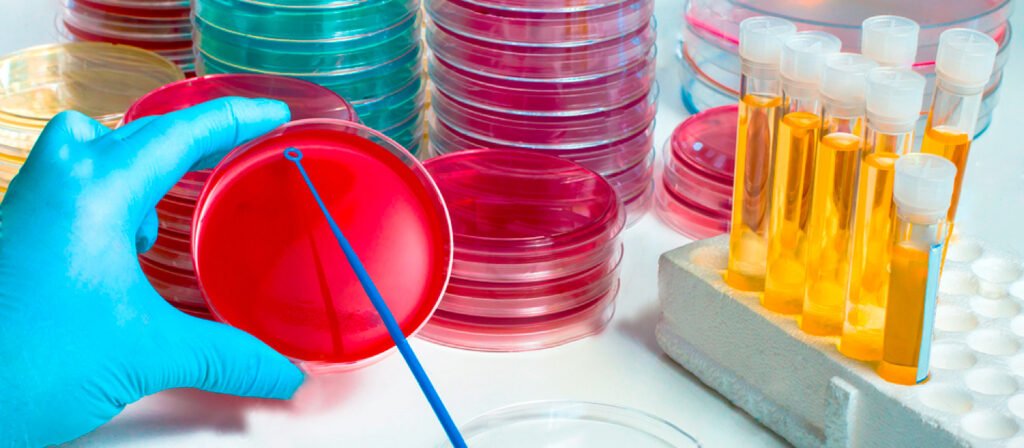

O que é o Ágar SS? Qual a função desse Meio de Cultura?
Você sabia que o Ágar SS é um componente essencial na microbiologia? Ele é responsável por uma série de funções importantes, desde a detecção de bactérias até o crescimento e isolamento de micro-organismos. Se você deseja saber mais sobre esse composto vital, continue lendo este artigo para descobrir tudo o que precisa saber sobre Ágar SS!
Ágar SS é o ágar Salmonella Shigella, Salmonella Shigella (SS) Agar é um meio de cultura moderadamente seletivo e diferencial para o isolamento, cultivo e diferenciação de Salmonella spp. e algumas cepas de Shigella spp.
O Ágar SS é uma modificação do Desoxycholate Citrate Ágar. É recomendado para testar amostras clínicas e testes de alimentos para a presença de Salmonella spp. e alguns Shigella spp.
O Ágar SS é um meio de cultura que é usado para cultivar bactérias e outros micro-organismos. Ele é feito a partir de uma mistura de ágar e soro de leite, que é est sterilizado antes de ser adicionado ao meio de cultura. O Ágar SS tem muitas vantagens em relação a outros meios de cultura, como o fato de ser menos propenso a contaminação e permitir um maior controle sobre as condições do ambiente.
A função do Ágar SS
O Ágar SS é um meio de cultura que é usado para cultivar microrganismos. Ele é feito a partir da secreção do estômago de animais e contém uma variedade de nutrientes que são necessários para o crescimento microbiano.
A principal função do Ágar SS é fornecer uma superfície onde os microrganismos podem se multiplicar. Ele também pode ser usado para isolamento bacteriológico, bem como para fazer suspensões microbianas mais concentradas.
O Ágar SS também é usado para análise de susceptibilidade antimicrobiana. Ele é frequentemente usado para testar a resistência de um microrganismo a diferentes antibióticos, permitindo que os médicos determinem qual medicamento eles devem usar para tratar uma infecção específica.
Princípio do Ágar Salmonella Shigella
A inclusão de sais biliares , citrato de sódio e verde brilhante servem para inibir organismos gram-positivos, coliformes e inibir a proliferação de Proteus spp., enquanto permite que Salmonella spp. para crescer .
Extrato de carne bovina, digestão enzimática de caseína e digestão enzimática de tecido animal fornecem fontes de nitrogênio, carbono e vitaminas necessárias para o crescimento do organismo.
A lactose é o carboidrato presente no Ágar SS. Tiossulfato e Citrato Férrico permitem a detecção de sulfeto de hidrogêniopela produção de colônias com centros negros. O vermelho neutro fica vermelho na presença de um pH ácido, mostrando assim que a fermentação ocorreu.
Usos de Ágar SS
O meio de cultura Ágar SS é usado para cultivar bactérias láticas em laboratório. É um meio de cultura sem sangue que contém glicerol e sacarose como fontes de carbono. O Ágar SS também é conhecido como Agar Saborless ou media M17.
É amplamente usado para viabilidade microbiana, crescimento bacteriano, diferenciação de bactérias lácticas e análise da sensibilidade à temperatura. O meio geralmente é usado em placas de Petri onde as bactérias são colocadas e incubadas por um determinado período de tempo antes de serem identificadas com ajuda de um microscópio.
- É usado como meio seletivo e diferencial para o isolamento de Salmonella e algumas espécies de Shigella de espécimes clínicos e não clínicos.
- Este meio não é recomendado para o isolamento primário de Shigella .
- Também foi desenvolvido para auxiliar na diferenciação de fermentadores de lactose e não-lactose de amostras clínicas, alimentos suspeitos e outras amostras desse tipo.
Preparação de Ágar Salmonella Shigela
- Suspenda 60,0 gramas de Ágar SS em 1000 ml de água destilada.
- Aqueça até a ebulição para dissolver o meio completamente.
- Não autoclave.
- Misture bem e despeje em placas de Petri estéreis.
Como interpretar o Ágar SS
A salmonela não fermentará a lactose, mas produzirá gás sulfídrico (H 2 S). As colônias bacterianas resultantes aparecerão incolores com centros pretos.
Shigella não fermenta lactose nem produz gás sulfeto de hidrogênio, então as colônias resultantes serão incolores.
As bactérias coliformes, como a E. coli , fermentam a lactose no meio, resultando no crescimento bacteriano com uma cor rosa. Eles não produzem sulfeto de hidrogênio.
Enterobacter e Klebsiella parecem maiores que E. coli , mucóide, pálido, creme opaco a rosa.
Controle de Qualidade em Salmonella Shigella Agar
Positivo
Salmonella enteriditis ATCC 13076= Colônias incolores com centro preto
Salmonella typhi ATCC 6539 = Colônias incolores com centro preto
Salmonella typhimurium ATCC 14028= Colônias incolores com centro preto
Shigella flexneri ATCC 12022 = colônias incolores
Negativo
Enterococcus faecalis ATCC 19433 = Inibido
Escherichia coli ATCC 25922 = Inibido
Enterobacter aerogenes ATCC 13048 = parcialmente inibido. Rosa-creme
Limitações do Salmonella Shigella Agar
- Recomenda-se que testes bioquímicos, imunológicos, moleculares ou de espectrometria de massa sejam realizados em colônias de cultura pura para identificação completa.
- A incorporação de verde brilhante neste meio o torna altamente seletivo e demonstrou inibir o crescimento de alguns Shigella
- Os sais biliares podem cristalizar com o tempo. Eles aparecem como pequenas bolas em forma de aranha dentro do meio e não afetam o desempenho do meio.
- Algumas cepas de Shigella , como sonnei e S. dysenteriae sorovar 1, podem fermentar a lactose de forma relativamente lenta, e as colônias mudam para a fermentação da lactose após o cultivo por 2 ou mais dias.
- Alguns organismos não patogênicos podem crescer em Salmonella Shigella
Composição do Ágar SS
Ingredientes Gms / Litro:
- Peptona 5.000.
- HM peptona B # 5.000.
- Lactose 10.000.
- Mistura de sais biliares 8.500.
- Citrato de sódio 10.000.
- Tiossulfato de sódio 8.500.
- Citrato férrico 1.000.
- Verde brilhante 0.00033.
- Vermelho neutro 0,025.
- Ágar 15.000.
- pH final (a 25°C) 7,0 ± 0,2.
O meio de cultura Ágar SS é um produto comercializado por várias empresas e utilizado para a preparação de amostras para microbiologia. É uma solução semissólida que contém glicerina, fosfato de sódio, cloreto de sódio e outros sais.
A principal função do meio de cultura Ágar SS é permitir o crescimento bacteriano em um ambiente controlado, fornecendo nutrientes essenciais às bactérias. Além disso, o meio de cultura Ágar SS também pode ser usado para isolamento e identificação de microrganismos.
Dúvidas sobre meios de cultura? Converse com nossa equipe.
AVISO DE DIREITOS AUTORAIS: Todo o material deste blog, sendo proibida toda e qualquer forma de plágio, cópia, reprodução ou qualquer outra forma de uso.
Qualquer dúvida técnica sobre os equipamentos contidos no portfólio SPLABOR, entre em contato com o Departamento de Vendas (sp@splabor.com.br)

A Splabor é uma empresa líder no ramo de fabricação de equipamentos para laboratório, especializada em oferecer uma ampla variedade de equipamentos para laboratórios, materiais e produtos para laboratório de alta qualidade.